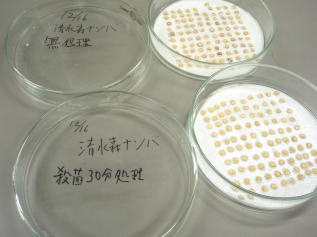

2008年12月21日 今年の清水森ナンバ(唐辛子)研究会 10大ニュース
★ 2008年の主なニュース
1. 斉藤秋義さん 収量第一位
2. トウガラシ博士(嵯峨紘一先生)インターネット検索で上位進出
3. ナンバおじさん(中田嘉博さん) ねぷた村 朝市の星になる
4. 吉川兼作さん 山田隆さん 弘大公開講座で盛り上がる
5. 会員増える 葛西さん夫妻トウガラシで愛を確認
6. ナンバの表彰ラッシュ・青ナンバ用ラベルと生産者証の発行
7. 清水森ナンバ 今年もマスコミを大いに賑わす
8. 加工センター「カリントウ」大人気
9. 前田先生 見参
10. 会長(農水省 地産地消の仕事人) ナンバの畑で遭難?
|
|
2008年12月19日 唐辛子(清水森ナンバ)の長老 今日も朝市で
先日、唐辛子(ナンバ)研究会の一部会員が集まり、今年の反省会を開催。また、今朝は朝市で頑張る吉川さんを訪問。1月10日で満86歳(私は12月28日が誕生日)。さすが12月末の寒さにも負けず、唐辛子(ナンバ)の一升漬を販売。これも「カプサイシン」の効果!
|
▼石田副会長や斉藤さん・中田さん・三上さん達と
当会の今年の10大ニュースを語る

|
▼朝市の吉川さん(右)と一升漬を持つ私

|
|
2008年12月15日 無加温ハウス(唐辛子)の清水森ナンバも間もなく終了
ナンバの無加温ハウス栽培も、県内気温ではもう限度。毎日雪模様です。
|
▼無加温ナンバのハウス

|
▼2008.12.15 雪の弘前公園 入口

|
|
2008年11月18日 青森県庁東京事務所より御紹介
「冬においしい青森の野菜」の取材。「大鰐温泉もやし」や「一町田のセリ」、そして「清水森ナンバ(唐辛子)」は、小林さんの畑で「Vegeta」和田さんの取材受けました。今夜は本格的雪の天気予報です。
|
▼一町田のセリの収穫

|
▼Vegeta 取材中

|
▼【取材翌日】一夜明けた青森は、天気予報が的中。取材陣の皆さんは無事帰れたでしょうか?
|

|
|
2008年11月10日 ナンバ(とうがらし)葉取り作業
11/10 初霜。園主の中田さんの畑で中村会長、ヤマトミ食品小野会長達とナンバ(とうがらし)葉取り作業を短時間行いました。どんな商品が出来るやら!
11/11 東目屋地方の畑は最低気温が-5℃、初雪でダウン。この後はハウスに期待!
|
▼2008 ナンバの葉の収穫

|
▼周囲もすっかり秋

|
▼霜からナンバを守る中田さん

|
▼日中でも5℃ 近くの岩木山も雪化粧

|
|
2008年10月26日 |
弘前大学農学生命科学部公開講座「世界のトウガラシと清水森ナンバの魅力」開催状況
〜 その4 〜
|
4部は清水森ナンバの加工品試食会です。青森県ふるさと食品研究センター、農産物加工指導センター、つがる農産物加工センターへ試供品の依頼をしておりました。八木橋明浩主任研究員が壇上にて、商品を手に清水森ナンバの加工品「カリントウ」や「サブレ」を紹介。続いて弘前市の駅前にある「五穀屋」の成田大番頭さんから「清水森ナンバ入りドーナツ」の紹介を頂きました。青森県特産品センターからは一味トウガラシなど4点。試食会の開催時間がちょうど12:30。とても美味しい時間帯でした。文京キャンパスの農学生命科学部前では、生徒さん達による、青ナンバや「清水森ナンバ」一味唐辛子をふりかけた焼鳥の販売が好評!ちなみに、講座の意見交換では貴重なご質問・ご意見などの交換が行われました。マル秘です。
|
▼加工センター八木橋さん
試供品「カリントウ」や「サブレ」の説明

|
▼五穀屋さんのPR

|
▼清水森ナンバしょうゆ漬や一味唐辛子

|
▼清水森ナンバ加工品の試食

|
|
2008年10月26日 |
弘前大学農学生命科学部公開講座「世界のトウガラシと清水森ナンバの魅力」開催状況
〜 その3 〜
|
公開講座会場は大勢の方が参加されました。2部は渋谷長生教授を聞き手に「清水森ナンバを守ってきた吉川さん」と私が登場。長老 吉川さんからは、土作りの大切さやナンバ粉を作った時の苦労体験談。「ナンバは現在(85歳)でも出来る年寄りの小遣いとして最適作物…」など。私は世界のトウガラシ25品種26点(後日、折に触れ画像で紹介します)の鉢植えを展示し、それぞれの特徴を解説しました。又、トウガラシとの出会い…など盛りだくさん。泣с}トミ食品・小野会長さんには、「清水森ナンバしょうゆ漬」について試食を含め解説を頂きました。
|
▼公開講座受講光景

|
▼渋谷教授と対談 吉川さんと私

|
▼世界のトウガラシの解説をする私

|
▼(有)ヤマトミ食品・小野会長さんの販売商品説明

|
|
2008年10月26日 |
弘前大学農学生命科学部公開講座「世界のトウガラシと清水森ナンバの魅力」開催状況
〜 その2 〜
|
コーディネーター渋谷長生教授から、農林水産省「立ち上がる農産漁村〜新たな力」選定や農林水産省・経済産業省より「農商工連携88選」の認定を受けたと紹介がありました。本多和茂准教授の講演は「清水森ナンバは他のトウガラシとここがちがう」。302講義室満員の状況で「とうがらしの遺伝子」など、市民にとっては分かりやすい内容でした。山田隆主幹からは「京野菜のブランド」や地元由来の他のトウガラシ産地「万願寺とうがらし」「伏見トウガラシ」、全国の「青トウガラシ」の状況を講演して頂き、関係者の励みとなった内容でした。弘大OBの中田嘉博さんからは、唐辛子実証圃の状況を中心に、作付けの秘話を講演していただきました。
この段階で非常に盛り上がり、すでに30分の予定オーバー。当日、事務方の農学生命科学部総務グループ係長(研究協力担当)三浦さんも来場者が続き、受付から離れられませんでした。
|
▼公開講座 コーディネーター 渋谷教授

|
▼本多和茂准教授の講演

|
▼山田主幹の講演

|
▼弘前大学OB 中田嘉博さん

|
|
2008年10月26日
|
弘前大学農学生命科学部公開講座「世界のトウガラシと清水森ナンバの魅力」開催状況
〜 その1〜
※その1〜その4に分割し、御紹介します。
|
公開講座前日。講師の吉川さん(85歳)が毎週土曜日(8:30〜12:30)出店する朝市を訪ね、出席の依頼確認。今日の天気は晴れですが、吉川さんは雨の日・雪の日も元気に営業しています。
公開講座当日。会場の準備をしながらコーディネーターの渋谷教授、本多准教授が吉川さんとの談笑。そして主催者を代表し、農学生命科学部地域連携推進室長
鈴木副学部長の開会の辞で幕を開けました。
|
▼公開講座出席前日の吉川さん

|
▼講座で使用する機器の点検

|
▼渋谷教授と吉川さん打ち合わせ

|
▼鈴木農学生命科学部副学部長による挨拶

|
|
2008年10月16日 外気温も低下 採種用果実の生育検証と一部確保
今日も普及指導室山田さんに同行をお願いし、会長と私は中田さんにお願いした実証圃へ。順調に生育しているナンバの生育検証と採種用果実の一部を確保。りんご収穫間近の忙しい作業中、お付き合いいただきました。
|
▼間もなく収穫 中田さんの美味しい「りんご」

|
▼実証圃で採種用果実の検証と一部確保

|
▼昨夜からの外気温 4℃〜22℃

|
▼肌寒さに耐えている赤ナンバ

|
|
2008年10月8日 「世界のトウガラシと清水森ナンバの魅力」公開講座
10月26日(日) 弘前大学農学生命科学部公開講座開催予告の打合会で実施要項が決まりました。試食や「世界のトウガラシ鉢植え」の展示もあります。詳細はこちら↓
迫る!弘前大学農学生命科学部公開講座のお知らせ
п@0172-39-1811 青森県特産品センター内 中村宛
|
▼公開講座準備打合会

|
▼加工センターの試作品

|
|
2008年10月2日 畑の巡回・救急車
9月28日〜30日までの3日間、朝9時から午後4時過ぎまでの集中講義を終了し、ホっとしたところで10月2日に栽培生産者会員の畑を巡回。赤ナンバの終盤が近づいてきました。巡回中、会長が用水路(深さ1m)に転落。救急車を呼んで私が添乗することになりました。幸いケガは打撲と2針縫う程度で、ホッとしました。
|
▼岩木山を背景に山田さんと会長と三人で畑巡回

|
▼最盛期を迎えた赤ナンバ

|
|
2008年9月17日 ナンバ(とうがらし)会員は大忙し 畑ではりんごが鈴なり
今日の気温は最低15℃、最高30℃。畑の巡回指導を実施。会員には夜電話で結果を連絡しました。
|
▼山田さん・会長と3人で巡回

|
▼ゴマ

|
▼鈴なりのりんご

|
▼りんご園でりんご丸かじりの観光客

|
|
2008年9月11日 赤ナンバ(唐辛子)も収穫の最盛期近づきました。
天気快晴。朝から普及指導室・山田主幹、中田実証圃担当、中村会長と私の4名は、栽培会員の畑6ヶ所を巡回指導。元気なナンバと出会ってきました。また、午後はつがる農産物加工センター公開デーに参加。ここでは「清水森ナンバ」赤一味や青しょうゆ漬などが展示され注目を集めておりました。その後、当会員三上社長さんに「岩木山麓の冷水(10℃)で育てているワサビ畑」を案内して頂き、ナンバと違う辛さを味わってきました。三上社長さん有難うございました。
|
▼小田桐さんの畑にて 右から山田主幹、私、中田さん

|
▼中田さんの畑にて 午後の参加者

|
▼左から三上社長さん、前田智雄准教授、私、中田さん

|
▼三上社長さんのわさび

|
|
2008年9月10日 弘前大学総合文化祭公開講座(2008.10.26 10:00〜13:00)の準備打合会を開催
当日の役割分担の概要をまとめました。主な内容を4テーマとし、渋谷長生教授をコーディネーターに、本多准教授の講演や清水森ナンバに関わる関係者が登壇。そして清水森ナンバ(唐辛子)を使用した試食品を食べたり、世界のトウガラシの鉢植えなどを間近で見たり・・・学外の参加者大歓迎です!詳細は後日お知らせいたします。
|
▼日本の代表的品種「鷹の爪」

|
▼南米原産「ロコテイーロ」

|
▼北中米の「ハラペノ」トウガラシ

|
|
2008年9月5日 試験研究機関の訪問
本多和茂准教授と私の後任の北大から着任した前田智雄准教授、私、そして専攻学生さんの皆と一緒に県農産物加工指導センターと県畑作園芸試験場の公開デーに参加しました。大学から約90qほど離れた南部地域です。加工指導センターでは農産物を活用した「清水森ナンバ」(とうがらし)等の試作品や、畑作園芸試験場では畑の見学をしました。多くの知人に会うことができました。
|
▼開発商品

|
▼青森県畑作園芸試験場の畑視察

|
▼庭田園芸部長、会長、山田主幹

|
▼本多准教授、私の後任・前田准教授、私、専攻学生さん

|
|
2008年8月30日 日本ベジタブル&フルーツマイスター協会
青森県農林水産政策課から紹介で、日本ベジタブル&フルーツマイスター協会・講師の山村友宏氏が、雨の中、当会の調査にお出でになりました。津軽藩ねぷた村の2Fの事務所で調査協力をし、その後、会がテストしている鉢植え「唐辛子」の前で山村さんと私の記念写真。
|
▼鉢植えの「清水森ナンバ」の前で

|
▼日本ベジタブル&フルーツマイスター協会

|
|
2008年8月28日 弘前大学にて「第3回東北育種研究集会が開催」
東北育種談話会主催の「第3回東北育種研究集会」において、本多和茂・相馬志穂・嵯峨紘一により弘前在来トウガラシ‘清水森ナンバ’の果実形態の特性というタイトルでポスター講演が行われ、併せて研究会の取り組みの紹介や製品の試食PRも行なわれました。
|

|
|
2008年8月27日 弘前市長さんへ表敬
青ナンバ(唐辛子)が最盛期を迎えたこの時期、当会の吉川、中田、ヤマトミ食品社長、中村会長と私、そして普及指導室 山田主幹に御同行頂き、6名はりんご農産課
広田課長さんの案内で相馬弘前市長さんへ表敬訪問。会の活動報告と現在販売している商品の紹介をしました。市長さんも「清水森ナンバのファン」との由、和やかな懇談のひとときでした。
|
▼清水森ナンバの京都視察談話

|
▼清水森ナンバの商品

|
▼弘前市長への清水森ナンバ活動報告

|
▼相馬弘前市長と
清水森ナンバを守り続けた吉川さん(85歳)

|
|
2008年8月22日 赤ナンバの収穫が目前です
会の事務局では鉢植えの清水森ナンバを10鉢栽培しております。栽培会員の集荷場所にナンバの生育度合いのモデルとして設置。 畑と比較して少し気温が高いと思われるため、生育は1週間ほど早いようです。
今は青ナンバの収穫が最盛期ですが、鉢植えの状況から赤ナンバの収穫も間もなく始まります。
|
▼清水森ナンバ 赤トウガラシ

|
|
2008年8月8日 青ナンバの生産は最盛期を迎えました
|
▼清水森ナンバ 青トウガラシ

|
賑やかな「ねぷた祭り」も終了し、今日は園地研修会。斎藤さん、嶽開発さん、中田さんの3ヶ所の畑で県中南県民局普及指導室の山田主幹、成田技師を招き開催しました。
今、青唐辛子は収穫の真っ最中です。参加の県総合販売戦略課((社)青森県ふるさと食品振興協会事務局)や生産者は、清水森ナンバの風味や辛味の度合いを確認し合っておりました。
「青ナンバも薄いグリーン色は辛味が少なく、シシトウ並。」
「濃い青で果肉が硬いのは、辛いナンバン好みのタイプです」
|
▼成田技師による病害虫対策

|
▼山田主幹の総合所見

|
▼嶽開発さんの担当者による解説

|
▼斎藤さんによる解説 圃場にて

|
▼車両10台に便乗

|
▼中田さんの圃場の参加者 岩木山をバックに

|
▼また、今日は新会員「五穀屋」さんの8月限定・清水森ナンバ入り『五穀おからドーナツ』の紹介がありました。唐辛子で暑さを乗り切ろうと製造したドーナツは大変好評でした。
|

|
|
2008年8月4日 世界のトウガラシ(唐辛子)と清水森ナンバの魅力 information
★お知らせ
平成20年10月26日(日) 弘前大学 農学生命科学部公開講座開催予定
名称 「世界のとうがらしと清水森ナンバの魅力」
場所 弘前大学農学生命科学部302講義室 定員70名
時間 10:00〜13:00
詳細は後日公表いたします。講座でご覧いただく予定の世界のトウガラシ(唐辛子)も順調に生育しております。
私の後任(弘前大学農学生命科学部)には、北海道大学農学部から前田智雄先生を准教授としてお迎えすることが出来ました。
尚8月8日の午前9:30 ナンバ(唐辛子)の研修会も行います。
|
▼世界のトウガラシ

|
▼前田先生、本多先生、私

|
|
2008年7月31日 選定・認定を受けました〜「立ち上がる農山漁村」「農商工連携88選」〜
◆2008年6月25日(東京都内にて)農林水産省より当研究会が「立ち上がる農山漁村」に、また私が在籍していた弘前大学農学生命科学部「地域環境科学科、生物生産科学科、生物機能科学科」が「立ち上がる農山漁村〜新たな力」に選定されました。選定式は代理で山田主幹と中村会長が参加しました。
◆2008年7月30日(宮城県仙台市にて)経済産業大臣・農林水産大臣より「農商工連携88選」に認定され中村会長と私が参加しました。会場では、弘前大学農学生命科学部の出身者から思わぬ声をかけてもらいました。
選定・認定を契機に一層の躍進を遂げたいものです。
|
▼「立ち上がる農山漁村」選定式 山田主幹と中村会長

|
▼ブランド確立研究会と弘前大学の選定書

|
▼「農商工連携88選」 認定式 嵯峨顧問

|
▼認定書

|
▼認定の盾
|
|
2008年7月10日 会員の相馬農協 巡回
会員の相馬農協さん(沢田地区 大沢さん他9名)は今年も猿害対策作物として作付けしました。私は弘大で授業があり、県普及指導室・山田主幹と中田さん(元加工センター所長)と事務局が現地指導をしました。猿害対策で悩んでいる当地区において、昨年は食害がなかったようでした。今年も挑戦しますが、元気に育っております。
近々「林檎の森(相馬農協直売所)」に清水森ナンバの青唐辛子が登場予定です。
|
|
2008年7月7日 野辺地にて
久々の休日。青森県野辺地港よりホタテ漁船に乗船、港から40分ほど陸奥湾沖合へ出船しました。清水森ナンバは、カレイやホタテの刺身や焼き肉のタレにもぴったりでした。
|

|

|
|
2008年7月5日 清水森ナンバ(唐辛子)栽培の畑巡回指導
7/1〜7/3の3日間、清水森ナンバを栽培している農家会員の現地訪問を行いました。メンバーは、私と県中南県民局普及指導室 山田隆主幹、中田嘉博(元県農産物加工センター所長)さん、当会の中村会長、事務局・加藤の5名です。今年のナンバ(唐辛子)の生育は、先日津軽地方を襲った「強風やヒョウ」の被害が多少見受けられましたが、元気に育っておりました。37ヶ所を巡回し、栽培面積の計測や会の栽培ルール管理状況などを確認。この間の巡回車の走行距離は約300qでした。今年産の美味しい青ナンバ販売は、まもなく始まります。楽しみにして下さい。
|
▼巡回中

|
▼畑巡回メンバー

|
▼三日目の後半は雨模様

|
|
2008年6月30日 国内外のトウガラシの育苗
本年10月26日、弘前大学農学生命科学部の学祭で「清水森ナンバ」をテーマにシンポジュームを計画しており、当日の参考展示用「国内外のトウガラシ(唐辛子)」20数品種を発芽させた画像です。
|
▼世界のトウガラシ
|

|

|
|
2008年6月27日 ひろさき産学官連携フォーラム
先日、弘前商工会議所を会場に「ひろさき産学官連携フォーラム20年度」が開催され、本多和茂准教授から「清水森ナンバ(唐辛子)」の特性解明についての講演がありまた。当日は、“マコモ”や“チシマザサ”、“りんご鹿角霊芝”、“都市型小型風力発電システム”、“水産資源の機能特性を活かした食品用途に関する研究”など、弘前大学の教員12名先生方の興味深い発表がありました。
|

|

|
|
2008年5月28日 清水森ナンバ苗の定植・研修会
今年の清水森ナンバ苗の「定植・研修会」は、中田嘉弘会員の実証圃で行いました。県中南地域県民局地域農林水産部 普及指導室主幹 山田さん指導のもと、新規会員を中心に総勢30名が参加。450本の苗の定植を行いました。この後、会員農家の皆さんが各自の畑で苗の定植をします。
また、弘前大学蔬菜・花卉園芸専攻の学生4名も私が引率で参加しました。
|
▼育苗した清水森ナンバの苗 畑に搬出

|
▼定植研修会

|
▼弘大専攻生も参加

|
▼定植と岩木山

|
|
2008年5月15日 JAつがる弘前・育苗センターで育っている清水森ナンバのポット苗
セル苗(200本入り)の配布が終わりました。次はポット苗です。生産者の皆さんに配布する予定の管理された苗も順調に育っております。
|
▼2本植

|
▼1本植

|
▼管理票も水浴び

|
|
2008年5月13日 セル苗配布とナンバ苗定植研修会
セル苗の配布後、ナンバ苗の植付け研修がありました。新規会員さんを主体に研修しましたが、既会員多くお集まりいただきました。
@ 日時:平成20年5月13日(火)15:30 〜 16:30
A 会場:津軽藩ねぷた村 弘前市亀甲町61
B 指導:普及指導室山田主幹・成田技師
事務局:青森県特産品センタ-
あいにく私は授業があり参加出来ませんでしたが、丁寧な指導を戴いたと報告を受けました。
|
▼研修会

|
▼普及指導室・成田技師

|
▼普及指導室・山田主幹

|
▼本日配布した清水森ナンバのセル苗

|
|
2008年5月12日 チョウセンゴヨウ
今年1月に清水森ナンバの一味唐辛子を販売しているアンテナショップ東京店にご来店の高野上様から頂き、春まで冷蔵庫の中で冷湿保管してあったチョウセンゴヨウ(2008年1月30日参照)。大学の実験室で清水森ナンバの播種試験にあわせ、4月6日セルトレイに播種後1ヶ月経過しました。72粒の種子から7つの発芽です。まずは、めでたし!残りはどうなるか試験観察中です。
|

|

|
|
2008年5月7日 清水森ナンバ 土壌検査
20年産作付けの土壌検査の状況を確認に中南地域県民局地域農林水産部普及指導室成田技師を訪ねました。ナンバは肥料と栄養バランスが大切です。会員個々に結果指導いたします。また消毒済みの種子からの苗は、順調に生育し、今年第一回目のセル苗は5月13日に配布予定です。
|

|

|
|
2008年4月15日 在来津軽清水森ナンバブランド確立研究会 総会
清水森ナンバの種まき(播種)を終え、その夜「清水森ナンバブランド確立研究会」の総会を開催。議事進行・司会は弘前大学 渋谷長生教授が受け持ち、吉川会員をはじめ生産者会員、ヤマトミ食品会員、JAつがる弘前、JA津軽石川、JA相馬村、県や市の行政関係者らが多数参加。今年の報告事項として「清水森ナンバ」に商標登録証が下りたことが大きな話題となりました。
役員の改選も行い、更なる飛躍を目指すことを「トウガラシ博士」から激励され、盛り上がった総会になりました。
|
▼嵯峨顧問挨拶・手前は渋谷教授、
右奥は本多准教授

|
▼事業計画の質問に答える中村会長

|
▼嶽開発さん・中田さん達からの
質問に答える会長

|
▼総会・事業計画の審議

|
|
2008年4月15日 清水森ナンバの種まき
今朝 、普及指導室 山田主幹・成田技師・事務局とJAつがる弘前育苗センターで「清水森ナンバ」の種まき作業(播種)の確認をしてきました。帰りには数q先にある鷲巣山に立ち寄りカタクリの花を観賞。夕方からは当会の総会です。
|
▼JAつがる弘前育苗センター前

|
▼メモを取る関係者
|
▼「清水森ナンバ」の商標登録証を
手にする齊藤さん

|
▼近くにある鷲巣山の今日のカタクリの花
|
|
2008年4月4日 「農商工連携88選」に清水森ナンバ
農林水産省と経済産業省において、農林水産業者と商工業者等が連携してそれぞれの技術や特徴等を活用している先進的な取組を「農商工連携88選」として選定。清水森ナンバもそのひとつに選定されました。
|
》》》 【農商工連携88選】の選定・公表について(PDF)
》》》 【農商工連携88選】 事例一覧(PDF)
|
|
2008年3月26日 第1回津軽遺産に清水森ナンバ
「残す・伝える・守る・ひろさき 市民が推薦し、市民が選んだ、すぐそばにある大切なもの。」第1回津軽遺産に「清水森ナンバ」が選ばれ、当会から4名が授賞式に参加しました。
|
▼認定式について

|
▼左から中田さん、吉川さん、嵯峨顧問、中村会長
|
▼吉川さんと並び受賞のコメントをする嵯峨顧問

|
▼在来種を守り続けた吉川さん(85歳)

|
|
2008年3月25日 清水森ナンバ 栽培研修会
清水森ナンバ(弘前在来トウガラシ)栽培に欠かせない要点について研修会を開催しました。中南地域県民局農林水産部普及指導室より、昨年の実証圃の結果や全体の収量結果を踏まえ丁寧な説明や今年の栽培の取り組み指導がありました。参加者は30名。会では、この後も研修会を開催します。
|
▼栽培研修会の様子

|
▼普及指導室による
ナンバの栽培と土壌について

|
▼顧問として挨拶

|
|
在来津軽清水森ナンバブランド確立研究会からのお知らせ information
1.今年第一回目の清水森ナンバの勉強会
@ 時期 3月25日(火)午後3時〜
A 場所 津軽藩ねぷた村
B 講師 普及指導室 山田隆主幹 成田恵美子技師
C 内容 「ナンバ栽培に欠かせない要点について」
2.土壌検査の準備
ナンバを植える畑の土を調べます。説明図をよく見て採って下さい。
@ 届ける期間 3月26日(水)〜4月4日(金)
(朝8時30分〜夕方5時まで 土・日もOKです)
A 場所 津軽藩ねぷた村
B 検査 普及指導室にお願いします
*募集致します・・・【新規会員】 ※但し厳格な入会条件があります。
○栽培条件 栽培地は弘前市・西目屋村・平川市・大鰐町です。
○栽培土壌検査を受けなければなりません。
○普及指導室等関係者の栽培指導を受けなければなりません。
○初回栽培者の栽培株数制限あり
○販売条件 厳格な規格・販売先制限あり
○加工条件 厳格な規格あり
【事務局】 青森県特産品センター
〒036-8332 青森県弘前市亀甲町61 0172-39-1811
詳細は会の事務局(中村.村山.須々田 宛)にお問い合わせ下さい。
|
|
2008年3月21日 農林水産省 『立ち上がる農山漁村』
農林水産省から平成19年度「立ち上がる農山漁村」選定事例に「在来津軽清水森ナンバブランド確立研究会」と、平成19年度「立ち上がる農山漁村〜新たな力〜」選定事例に弘前大学農学生命科学部(地域環境科学科・生物生産科学部・生物機能科学部)が選定されたと、「立ち上がる農山漁村」有識者会議 林
良博 座長より平成20年3月12日付けで通知がありました。詳しい内容は選定証の授与を含めて後日送付戴くとの事でした。
|
》》》農林水産省【立ち上がる農山漁村】についてはこちらから
|
|
2008年3月13日 清水森ナンバ 苗の準備に向けて
3月13日 天気 快晴
JAつがる弘前農業協同組合販売部の育苗センターで、関係者と今年の苗を作るためスケジュールを打合せしました。
詳細はまだ分かりませんが、「清水森ナンバ」ブランド確立研究会に農林水産省から、平成19年度「立ち上がる農山漁村・〜新たな力〜」選定事例3団体に選ばれたとの連絡がありました。
|
▼販売課育苗 齊藤係長さん

|
▼育苗センター入口にて関係者と

|
▼育苗センター隣の畑で出会った農業用ヘリ

|
▼りんごの樹の枝剪定と岩木山

|
|
2008年3月11日 農水クラスター事業 (財)食品産業センター
3月10日に(財)食品産業センター、潟uランド総合研究所の皆さんが「清水森ナンバ」ブランド確立研究会の事務局がある弘前市に「地域食品ブランド維持・管理対策事業」のヒアリング、アドバイス視察においでくださいました。当日は「清水森ナンバ」の関係者、(社)ふるさと食品、中田実証圃担当、三上会員
、中南普及指導室、ヤマトミ食品、青森県特産品センターと顧問の私を合わせて12名が出席。栽培、ブランド化など盛り上がった意見交換が行われました。
|
▼ねぷた村の売り場でナンバを手に

|
▼当会に聞き取り調査

|
|
2008年2月22日 清水森ナンバ加工懇談会
在来津軽「清水森ナンバ」ブランド確立研究会会長より、中南地域県民局主催「攻めの普及」による売れる商品づくり・清水森ナンバ加工懇談会が開催された状況の報告受けました。当日は、ヒット商品「おからこんにゃく」を誕生させた菜食料理研究家 岡田哲子氏を迎え楽しい講話や、活発な意見交換会と試食会があったとの事でした。
|
▼「おからこんにゃく」岡田氏を迎えて

|
▼加工について活発な意見交換

|
|
2008年2月21日 清水森ナンバ(弘前在来トウガラシ)の祖先は伏見トウガラシ
「長屋王家木簡」を研究されている、京都市左京区の野菜文化史研究センター 所長 久保 功 先生から「(財)伏見稲荷大社講務本庁 第176号」を送って頂きました。その書の中で「生活木簡に新世紀こころの糧を視る」と題されてトウガラシについて述べられておられます。以下抜粋内容をご紹介いたします。
『トウガラシは、コロンブスも介在し日本にはポルトガル人により鉄砲伝来(1543)と共に伝えられたという説。それが伏見の先人達に育てられ、400年を超える歴史に今「伏見とうがらし」の名で全国のファンを魅せています。朝鮮通信史を江戸城に迎えた折の饗応膳には超高級香辛料 「タウガラシ」を加えています。
関ヶ原合戦以後、伏見城で家康にも拝謁した弘前藩藩主、津軽為信公が伏見稲荷近辺から持ち帰った「伏見唐芥子」は今世紀に入って地元各界連携で在来津軽「清水森ナンバ」ブランド確立研究会を立ち上げ、事業に取り組んでいます。遠く津軽の地で伏見の銘品が輝きつづけているのはうれしいことです。』
又 先生のお手紙には【清水森ナンバの先祖は伏見稲荷周辺】、と記されておりました。
|
|
2008年2月18日 トウガラシのルーツ |

|
出典 : J. Andrewsが"Peppers the Domesticated Capsicums"で表したものを
矢澤進先生が“トウガラシ 辛味の科学”で邦訳したものです。
因みにその単行本の編者は岩井和夫先生と渡辺達夫先生です。
|
|
2008年2月6日 種子の確認
昨年10月、採種用圃場から苗用に選抜採取した清水森ナンバ果実の種子16,000粒を、丁寧に確認する作業を行いました。ガーゼ梱包作業中、渋谷長生教授もひょっこり見学。目が疲れた一日でした。
|
▼種子消毒の前処理

|
▼選抜した種子の確認

|
▼乾燥した清水森ナンバ果実

|
▼偵察・渋谷教授

|
|
2008年1月30日 チョウセンゴヨウの松笠(マツカサ)
「清水森ナンバ(弘前在来トウガラシ)の一味唐辛子」を販売している東京のアンテナショップにて、ご来店の高野上様から貴重な「チョウセンゴヨウ(朝鮮五葉:マツ科)の松笠」を戴いたとの事。発芽試験をしてみようと数個割ってみました。弘前大学周辺は今、冬の一番厳しい季節です。春まで冷蔵庫中で冷湿保管します。
|
▼チョウセンゴヨウ大きい笠松

|
▼松ヤニと硬い笠松に包まれた種子

|
▼ニッパとカッターで割った実

|
▼栄養価の高い実

|
|
2008年1月28日 種子保存のための殺菌作業
以前、清水森ナンバ栽培会員へ苗配布用の種子保存のため殺菌作業を行った思い出の画像です。 次亜塩素酸ソーダ溶液を薄め、添着剤を少量含ませた溶液に種子を漬け殺菌後、
素早く乾燥させ保存したときの作業光景です。
|

|

|

|

|
|
2007年12月19日 「清水森ナンバ」優良選抜された種子の健康テスト
本年度の清水森ナンバ(品種:弘前在来トウガラシ)は赤トウガラシ、青トウガラシ合わせて約9トンの収穫がありました。すでに来年の栽培に向け「トウガラシ種子発芽試験法」に基づき、発芽床(シャーレ・径12p)に種子100粒を入れ発芽の状況を検証中。来年度用の元気度を確認しました。
|
▼種子の優良選抜

|
▼100粒の種子
|
▼3日目の発芽

|
▼発芽チェック

|
|
2007年12月7日 在来津軽清水森ナンバブランド確立研究会の成果発表
前日、栽培者・県・市の関係者・研究機関・弘前大学から調査、研究発表がありました。内容は次の通りです。
@ クラスター事業内容 A 苗 B 土壌検査と栽培暦 C 19年度実証圃の結果
D トウガラシ加工状況 E 清水森ナンバのレシピ集 F 乾燥時における褐変
G 遺伝子 H 播種・巡回・採種 I 農水省クラスター調査 J 本年産赤一味
|
▼弘大 渋谷長生教授のコーディネーターにて

|
▼遺伝子は弘大 本多和茂・石川隆二、両准教授

|
▼実証圃の検証報告

|
▼清水森ナンバを守り続けた吉川さん(84歳)の活躍
私の巡回中、畑にて

|
|
2007年12月6日 加工状況の報告
12月6日、畑は雪。
本年度産の加工品も出揃いました。 乾燥を終えた本年産の在来津軽「清水森ナンバ」赤唐辛子の一味が販売開始(※販売場所 : 津軽藩ねぷた村の売店(社)青森県ふるさと食品振興協会アンテナショップ弘前店 / 東京都中央区新富町1-3-9東光ビル1F アンテナショップ東京店(同上))
。青トウガラシの生果について、 ヤマトミ食品さんは商品名「青ナンバしょうゆ漬」 、秋田屋さんは 商品名「さもだし南蛮漬」に加工して販売しております。
料理飲食業では、弘前市内レストラン山崎さん、杏さん、等で提供しております。
|
▼人気の在来津軽清水森ナンバ一味唐辛子

|
|